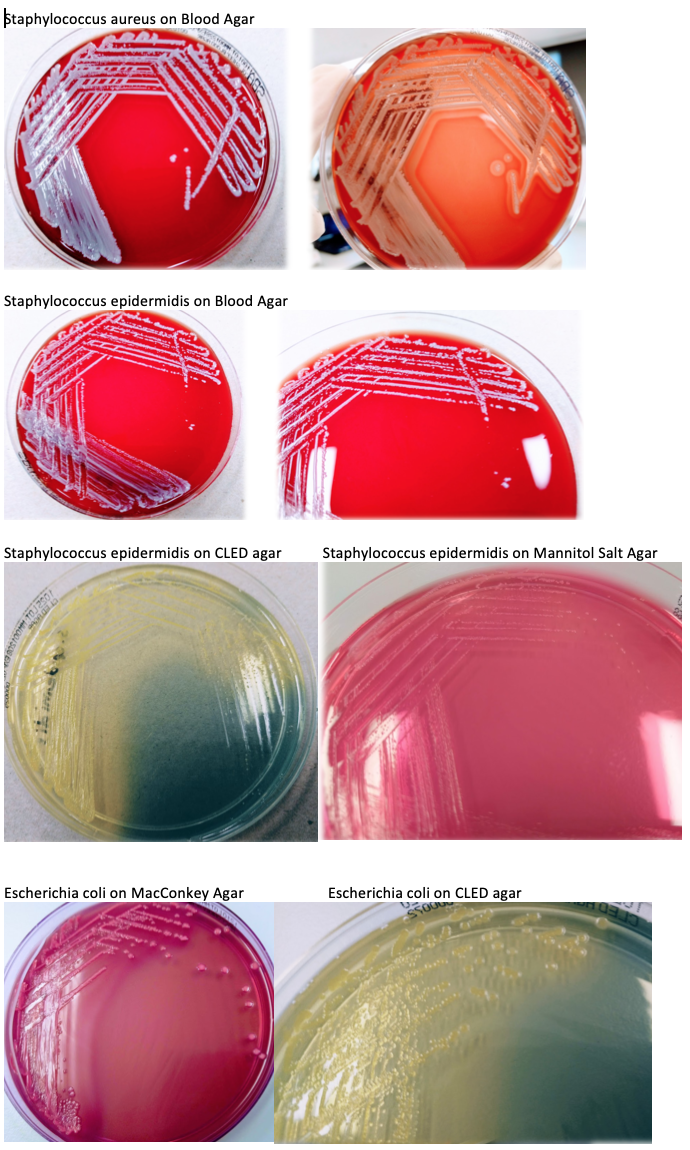
Solved More Microbiology Questions A Name A Bacteria Th Chegg Com

E coli morphology on blood agar 338684-Does e coli grow on blood agar
Blood agar is one type of differential medium, allowing bacteria to be distinguished by the type of hemolysis produced Some differential media are also selective, for example, standard enteric agars such as MacConkey and EMB agars, which are selective for gramnegative coliforms and can differentiate lactosefermenting and nonlactoseColonies of Escherichia coli isolated on MacConkey agar from various clinical specimens, allowed to identify 5 classes of morphological vari ants of the colonies or Colonial Morphology, thanks toNaegleria fowleri can be cultured on nonnutrient agar plates coated with Escherichia coli or Enterobacter aerogenes The amebae will feed on the bacteria, multiply, and differentiate into cysts within a few days
Staphylococcus Aureus And Ecoli Under Microscope Microscopy Of Gram Positive Cocci And Gram Negative Bacilli Morphology And Microscopic Appearance Of Staphylococcus Aureus And E Coli S Aureus Gram Stain And Colony Morphology On Agar Clinical
Does e coli grow on blood agar
Does e coli grow on blood agar-A, Blueviolet pigment of Kluyvera spp growing on sheep blood agar This Kluyvera sp resembles the colony morphology of Escherichia coli growing on MacConkey (MAC) agar B, Appearance of K cryocrescens growing on MAC C, Appearance of K ascorbata growing on MAC agarFermentation, and those that produced grey colonies of expected morphology for E coli on Columbia blood agar, were subjected to a final species confirmation using an API E test kit (bioMérieux, Nürtingen, Germany) All isolates were stored in cryobank tubes (Mast Diagnosica GmbH, Reinfeld, Germany) at 80 C



E Coli On Macconkey Agar Blood Agar And Chocolate Agar Youtube
The shape of Ecoli colonies in nutrient agar is circular while in blood agar is irregular The size for this bacteria colony is around 1mm to 2mm The size of the agar is measure by finding a single colony and diameter of the colony using ruler To observe the edge of a colony, we need to look at the end of the bacterial colonyE coli is a gramnegative bacillus that grows well on commonly used media It is lactosefermenting and betahemolytic on blood agar Most E coli strains are nonpigmented Escherichia coli on Gram stainEscherichia coli is first isolated by Escherich in 15 Escherichia coli is the most important species encountered as a human pathogen Most commonly found in human and animal intestine There is various form of Escherichia coli present in nature Morphology of Escherichia coli Escherichia coli is a gramnegative, nonsporing, bacillus
A Betahemolytic on sheep blood agar B Colorless colonies on MacConkey agar C Colorless colonies on xyloselysinedesoxycholate agar D Green colonies with black centers on Hektoen enteric agarMorphology of E coli E coli is gramnegative (ve) rodshaped bacteria It is 13 x 0407 µm in size and 06 to 07 µm in volume It is arranged singly or in pairsOn Endo agar it looks like lactose negative)
MORPHOLOGY OF ESCHERICHIA COLI (E COLI) Shape – Escherichia coli is a straight, rod shape (bacillus) bacterium Size – The size of Escherichia coli is about 1–3 µm × 04–07 µm (micrometer) Arrangement Of Cells – Escherichia coli is arranged singly or in pairsEscherichia coli EVERETTC SHORT, JR, AND HAROLDJ KURTZ College of Veterinary Medicine, University of Minnesota, St Paul, Minnesota Receivedfor publication 16February 1971 Someproperties ofthe cellfree andcellassociated hemolysins ofEscherichia coli were studied Several strains ofE coli that were isolated from intestines of pigsNoticeably, on casein soy peptone (CASO) sheep blood agar and Columbia blood agar, enterococci grew with two different phenotypes a normal phenotype and an SCV phenotype with much smaller colonies (Fig 1) Pulsedfield gel electrophoresis (PFGE) confirmed the clonal identity of the two phenotypes (Fig 2)


Staphylococcus Aureus And Ecoli Under Microscope Microscopy Of Gram Positive Cocci And Gram Negative Bacilli Morphology And Microscopic Appearance Of Staphylococcus Aureus And E Coli S Aureus Gram Stain And Colony Morphology On Agar Clinical



Microbiology Atlas Of Enterobacteriaceae Free Medical Atlas
This exercise will help you identify the cultural characteristics of a bacterium on an agar plate called colony morphology Although one might not necessarily see the importance of colonial morphology at first, it really can be important when identifying the bacterium Features of the colonies may help to pinpoint the identity of the bacteriumA Betahemolytic on sheep blood agar B Colorless colonies on MacConkey agar C Colorless colonies on xyloselysinedesoxycholate agar D Green colonies with black centers on Hektoen enteric agarFor example, sorbitol can be used as a replacement sugar in MacConkey agar to assist in the isolation and differentiation of enteropathogenic E coli serotypes such as E coli O157H7 by the presence of white circular colonies that are nonsorbitol fermenting Preparation of MacConkey Agar



Urine Culture Interpretation Identification And More Lab Tests Guide



Escherichia Coli Lecture
When the agar cools and solidifies, it diffuses back in, creating a gradient of oxygen concentrations in the medium This makes the top aerobic and the bottom anaerobic to support a large range of microorganisms Agar deep stabs are stabinoculated with a sterile inoculating needle This is to introduce as little air as possible and theBacterial Morphology E faecalis on blood agar;E coli is a gramnegative bacillus that grows well on commonly used media It is lactosefermenting and betahemolytic on blood agar Most E coli strains are nonpigmented Escherichia coli on Gram stain



Meningitis Lab Manual Primary Culture And Presumptive Id Cdc



The Who S Who Of E Coli Strains Microbiologics Blog
Escherichia coli is first isolated by Escherich in 15 Escherichia coli is the most important species encountered as a human pathogen Most commonly found in human and animal intestine There is various form of Escherichia coli present in nature Morphology of Escherichia coli Escherichia coli is a gramnegative, nonsporing, bacillusThe genus Escherichia is named after Theodor Escherich, who isolated the type species of the genus Escherichia organisms are gramnegative bacilli that exist singly or in pairs E coli isBlood Agar Colonies of Ecoli on blood agar 1 – 4 mm diameter after overnight incubation Colonies may also appear mucoid and some strains of Ecoli is hemolytic Ecoli Growth on Blood Agar


Clostridium On Blood Agar Introduction Pathogenecity Laboratory Diagn



Escherichia Coli Morphology Lab Diagnosis Notesmed Notesmed
CLED Agar is an abbreviation for Cystine Lactose ElectrolyteDeficient AgarIt is a type of differential medium recommended for diagnostic urinary bacteriology The medium supports the growth of all urinary potential pathogens and provides distinct colony morphologyEscherichia coli (E coli) is the most famous member of the coliform group bacteria that is almost exclusively of fecal origin In some cases it is involved in food poisoning, certain strains causing gastroenteritis (such as serotype O157H7 and other enterovirulent Ecoli E coli is often used in molecular biology as it is easy to culture ItE coli is a gramnegative, rodshaped, facultative anaerobic bacterium that belongs to family Enterobacteriaceae It is a faecal coliform bacterium commonly found in the lower intestine of warmblooded organisms Many E coli strains are harmless, and they are a part of the normal microbiota of the gut that keeps our gut healthy



Bam Chapter 4a Diarrheagenic Escherichia Coli Fda



Culture Characteristics Of E Coli On Different Media Download Table
Produces opaque, graywhite, smooth, shiny, round, convex colonies that are nonhemolytic (gamma) on blood agar E coli is a member of the Enterobacteriaceae that inhabits the human GI tract and that of many animals There are a variety of different strainsFermentation, and those that produced grey colonies of expected morphology for E coli on Columbia blood agar, were subjected to a final species confirmation using an API E test kit (bioMérieux, Nürtingen, Germany) All isolates were stored in cryobank tubes (Mast Diagnosica GmbH, Reinfeld, Germany) at 80 C(A) Staphylococcus aureus, (B) Staphylococcus epidermidis, and (C) Escherichia coli streaked on a mannitol salt agar plate The mannitol fermenting colony (yellow) is S The growth of E coli was inhibited by the high salt concentration



E Coli P Aeruginosa S Aureus And S Epidermidis Bacteria Colonies On Blood Agar


Www Com Documents Legacy Brochures Microbiology Solutions Prepared Culture Media Ds Pm l Prepared Plated Media Br En Pdf
Eosin Methylene Blue (EMB) Agar Non lactose fermenters, including Salmonella, Shigella and Proteus forms colorless or transparent coloniesThe shape of Ecoli colonies in nutrient agar is circular while in blood agar is irregular The size for this bacteria colony is around 1mm to 2mm The size of the agar is measure by finding a single colony and diameter of the colony using ruler To observe the edge of a colony, we need to look at the end of the bacterial colonyADVERTISEMENTS The following points highlight the three main mediums of Identification of Bacterial Growth the mediums are 1 Growth on Nutrient Agar 2 Blood Agar 3 MacConKey's Agar Medium # 1 Growth on Nutrient Agar (Table 72) Steps to be adopted ADVERTISEMENTS 1 Observe and record the morphology of colony and pigment production in nutrient



Escherichia Coli E Coli An Overview Microbe Notes



Figure 3 Hemolytic Escherichia Coli Inhibits Swarming And Differentiation Of Proteus Mirabilis Springerlink
1 Which of the following reactions is typical for Escherichia coli?The strain of bacteria is identified when using MacConkey Agar The very essence of MacConkey agar is to differentiate between lactose fermenting and nonlactose fermenting gramnegative bacteria Examples are as follows Lactose fermenting – Enterobacter aerogenes, Escherichia coli, and KlebsiellaWhen the agar cools and solidifies, it diffuses back in, creating a gradient of oxygen concentrations in the medium This makes the top aerobic and the bottom anaerobic to support a large range of microorganisms Agar deep stabs are stabinoculated with a sterile inoculating needle This is to introduce as little air as possible and the



Growthmedia


Vetbact
For pus & urine sample, Blood Agar and MacConkey agar are commonly used Proteus grow on the Blood Agar plate in successive waves to form a thin filmy layer of concentric circles (swarming) Proteus do not swarm in the MacConkey agar medium and form smooth, pale or colourless (NLF) colonies Swarming in Blood Agar (Source)May 3, 14 Escherichia coli colonies on blood agar, Ecoli colonies1 Which of the following reactions is typical for Escherichia coli?



Escherichia Coli Colony Morphology And Microscopic Appearance Basic Characteristic And Tests For Identification Of E Coli Bacteria Images Of Escherichia Coli Antibiotic Treatment Of E Coli Infections


Www Com Documents Legacy Brochures Microbiology Solutions Prepared Culture Media Ds Pm l Prepared Plated Media Br En Pdf
Colonies of Escherichia coli isolated on MacConkey agar from various clinical specimens, allowed to identify 5 classes of morphological vari ants of the colonies or Colonial Morphology, thanks toColumbia blood agar had raised centers and narrow, flat edges The average diameter of the colonies after 72 h of incubation at 37°C was 2 mm Figure la shows an entire colony of C jejuni that had been removed from the agar surface and mounted on an SEMspecimen stub Figure lb showsa magnified areaofthe edge ofthe colony in Fig laEMB media assists in visual distinction Escherichia coli,other nonpathogenic lactosefermenting enteric gramnegative rods, and the Salmonellaand Shigellagenera Escherichia colicolonies on EMB agar (Note greenish metallic sheen) Differentiation between these gramnegative bacilli is based on the colony color



Morphology Culture Characteristics Of Klebsiella Pneumoniae



Culture Characteristics On Different Media And Biochemical Reaction Of Download Table
Escherichia coli Four different strains of Escherichia coli on Endo agar with biochemical slope (see here) Glucose fermentation with gas production, urea and H2S negative, lactose positive (with exception of strain D " late lactose fermenter ";Tryptic Soy Agar, Nutrient Agar, Blood Agar 5% For selective isolation MacConkey Agar, EMB Agar, MacConkey with Sorbitol ( E coli O157) For maintenance Tryptic Soy Agar, Nutrient Agar, Blood Agar 5% For longterm storage at 70 degrees C, TSB with 15% Glycerol or Skim Milk Media is recommendedNaegleria fowleri can be cultured on nonnutrient agar plates coated with Escherichia coli or Enterobacter aerogenes The amebae will feed on the bacteria, multiply, and differentiate into cysts within a few days



Enterobacteriaceae Microscopic Appearance Cultural Characteristics Ppt Video Online Download



Pseudomonas Aeruginosa Colony Morphology On Macconkey Agar Blood Agar Clear Explain Youtube
A Betahemolytic on sheep blood agar B Colorless colonies on MacConkey agar C Colorless colonies on xyloselysinedesoxycholate agar D Green colonies with black centers on Hektoen enteric agarOn Endo agar it looks like lactose negative)1 Which of the following reactions is typical for Escherichia coli?



E Coli Colony Morphology On Blod Agar Colonies Without Hemolysis



Cultivation Media For Bacteria
Staphylococcus aureus and Escherichia coli are among the most prevalent species of grampositive and gramnegative bacteria, respectively, that induce clinical mastitis The innate immune system comprises the immediate host defense mechanisms to protect against infection and contributes to the initial detection of and proinflammatory response to infectious pathogensChocolate agar is used for the isolation of fastidious organisms, such as Haemophilus influenzae, when incubated at 3537°C in a 5% CO2 atmosphere The composition of chocolate agar and the Blood Agar is the same and the only difference is while preparing chocolate agar, the red blood cells are lysedEscherichia coli cultivated on blood agar Cultivation 24 hours in an aerobic atmosphere, 37°C Colonies are without hemolysis but many strains isolated from infections are betahemolytic Escherichia coli is commonly found in the lower intestine of warmblooded organisms (endotherms) Most E



Common Bacterial Scents Microbiology Learning The Why Ology Of Microbial Testing



Toxins Free Full Text Genetics Toxicity And Distribution Of Enterohemorrhagic Escherichia Coli Hemolysin Html
Escherichia coli or Ecoli cells may grow on a solid or in a liquid growth medium under a laboratory condition Solid and liquid media may have exactly the same composition except that the solid medium contains an extra 15% agar Different Ecoli clones may have different properties Colonies growing on solid mediaEscherichia coli Four different strains of Escherichia coli on Endo agar with biochemical slope (see here) Glucose fermentation with gas production, urea and H2S negative, lactose positive (with exception of strain D " late lactose fermenter ";E coli is a gramnegative bacillus that grows well on commonly used media It is lactosefermenting and betahemolytic on blood agar Most E coli strains are nonpigmented The image below shows



Macconkey Agar Mac Composition Preparation Uses And Colony Characteristics Learn Microbiology Online



Bacterial Screenshot Presentation 2
Chocolate agar is used for the isolation of fastidious organisms, such as Haemophilus influenzae, when incubated at 3537°C in a 5% CO2 atmosphere The composition of chocolate agar and the Blood Agar is the same and the only difference is while preparing chocolate agar, the red blood cells are lysed


Asm Org Getattachment 8dce45e8 Caeb 4ed8 B5d1 94e4946d79 Phenylethyl Alcohol Agar Protocol Pdf


Q Tbn And9gcrms9unbv Vkuyxncf3l8pazjer7kpldtl5197uyxnhytggyw2u Usqp Cau



How To Read A Culture Plate



Abis Encyclopedia



Phenylethyl Alcohol Blood Agar Pea Anaerobe Systems


Staphylococcus Aureus And Ecoli Under Microscope Microscopy Of Gram Positive Cocci And Gram Negative Bacilli Morphology And Microscopic Appearance Of Staphylococcus Aureus And E Coli S Aureus Gram Stain And Colony Morphology On Agar Clinical


Elizabethkingia Meningoseptica Wikipedia


1



Laboratory Features Of Escherichia Coli


Vetbact



Escherichia Coli E Coli Meaning Morphology And Characteristics



Escherichia Coli Morphology Lab Diagnosis Notesmed Notesmed


Small Things Considered A Whiff Of Taxonomy Granulicatella And Abiotrophia



Escherichia Coli Wikipedia



E Coli On Macconkey Agar Blood Agar And Chocolate Agar Youtube


Www Jfmed Uniba Sk Fileadmin Jlf Pracoviska Ustav Mikrobiologie A Imunologie Enterobacteriaceae Campylobacter Helicobacter Pdf


Preparation Of Blood Agar Medium From Trypticase Soy Agar Base



Welcome To Microbugz Macconkey Agar



Isolation And Microbiological Identification Of Bacterial Contaminants In Food And Household Surfaces How To Deal Safely Othman As Egypt Pharmaceut J



Escherichia Coli



E Coli Non Hemolytic Colonies On Blood Agar Gamma Hemolysis



Escherichia Coli E Coli An Overview Microbe Notes


Vetbact



Pdf Colonial Morphology Of Escherichia Coli Impact Of Detection In Clinical Specimens



Staphylococcus Epidermidis An Overview Sciencedirect Topics



Bam Chapter 4a Diarrheagenic Escherichia Coli Fda



Escherichia Coli E Coli An Overview Microbe Notes

Solved More Microbiology Questions A Name A Bacteria Th Chegg Com



Characterization Of Clinical Enterococcus Faecalis Small Colony Variants Journal Of Clinical Microbiology



Enterobacteriaceae Cultural Characteristics Microbe Notes



E Coli Colony On Macconkey Agar Blood Agar Nutrient Agar Microbiology Youtube



Oral Mucosal Microbes Sciencedirect


Q Tbn And9gcs Botvbbukoxdcwryz0rf 2dji0ldkyzb11lezpg2lqwg3skjk Usqp Cau



Phenylethyl Alcohol Blood Agar Pea Anaerobe Systems



Media Used For Bacterial Growth Microbiology Health And Disease



Escherichia Coli Wikipedia



Pathology Outlines Klebsiella Oxytoca



Macconkey Agar Youtube



E Coli On Emb Agar Colony Morphology Results Why What Youtube


Escherichia Coli Colonies On Blood Agar E Coli Colonies



Mucoid Escherichia Coli In Cystic Fibrosis Nejm



Escherichia Coli E Coli An Overview Microbe Notes



Enterobacteriaceae Family Ppt Video Online Download



Morphology Culture Characteristics Of Escherichia Coli E Coli



Selective Growth Media For Differentiation And Detection Of Escherichia Coli And Other Coliforms Sigma Aldrich



Salmonella Shigella Ss Agar Composition Principle Procedure And Results Learn Microbiology Online



I Ve Attached Lab Worksheets And Images Phenylet Chegg Com


Http Www Globolab De Jinfectdevctriesdoijidc57 Pdf



Nutrient Agar



The Who S Who Of E Coli Strains Microbiologics Blog



Bacteria E Coli P Aeruginosa S Aureus S Epidermidis On Blood Agar Colony Morphology



Solved Test Procedure Cellular Morphology Gram Stain Endo Chegg Com



Pin On Microcosmos



Pin On Demo Lesson Cell Division


Www Jfmed Uniba Sk Fileadmin Jlf Pracoviska Ustav Mikrobiologie A Imunologie Enterobacteriaceae Campylobacter Helicobacter Pdf



Escherichia Coli Don Xavier N D Morphology Gram Negative Oxidase Negative Non Sporing Non Capsulated Bacillus Strains Of E Coli Are Usually Motile Ppt Download



Pathology Outlines Klebsiella Oxytoca


Aem Asm Org Content 14 2 152 Full Pdf



Pathogenic Bacteria And Identification Microbiology Learning The Why Ology Of Microbial Testing



Macconkey Agar Mac Composition Preparation Uses And Colony Characteristics Learn Microbiology Online


Q Tbn And9gct3rvwxdktucejf0e Hcszhyy74y7oosiy E Wt3csrkncgvp Usqp Cau


Gram Negative Bacilli Of Klebsiella Pneumoniae Medical Laboratories



Isolation Of Foodborne Pathogens On Selective Differential And Enriched Medium By Streak Plating Springerlink



Genus Escherichia Coli



Escherichia Coli Colony Morphology And Microscopic Appearance Basic Characteristic And Tests For Identification Of E Coli Bacteria Images Of Escherichia Coli Antibiotic Treatment Of E Coli Infections



Detection And Discrimination Of Bacterial Colonies With Mueller Matrix Imaging Scientific Reports



Thymol Tolerance In Escherichia Coli Induces Morphological Metabolic And Genetic Changes Bmc Microbiology Full Text



E Coli Diagnosis Procedure And Interpretation Lab Tests Guide



Streptococcus An Overview Sciencedirect Topics



Cureus Evaluation Of Virulence Factors And Antibiotic Sensitivity Pattern Of Escherichia Coli Isolated From Extraintestinal Infections



Growth Requirements Of E Coli And Auxotrophs Microbiology Class Video Study Com



Macconkey Agar Culture Media Microbe Notes



Enterobacteriaceae Basics


Cled Agar Introduction Uses Composition Preparation Colony



E Coli Colony Morphology On Macconkey Agar Plate Presumptive Download Scientific Diagram



Macconkey Agar Composition Principle Uses Preparation And Colony Morphology



コメント
コメントを投稿